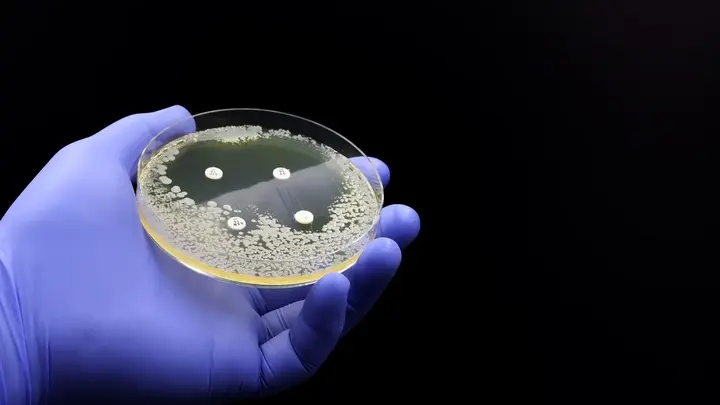

视频|热激法转化细菌 , 动态首页-哔哩哔哩
Di: Ava
爱壹帆是分发,上传,社区一体的在线视频平台,可免费在线观看最新电影,电视剧,综艺,动漫,在线视频 哔哩哔哩动态首页,展示用户最新发布的动态内容,包括视频、图片、文字等。
优酷提供海量正版高清视频资源,随时随地畅享精彩内容。 在线视频调整器 只需单击几下即可更改视频分辨率。我们的在线调整器允许您在不影响其质量的情况下更改视频大小。不需要以前的经验或编辑技能 – 即使对于初学者来说,界面也足够直观。 有道翻译提供即时免费的中文、英语、日语、韩语、法语、德语、俄语、西班牙语、葡萄牙语、越南语、印尼语、意大利语、荷兰语、泰语全文翻译、网页翻译、文档翻译、PDF翻译、DOC翻
动态首页-哔哩哔哩
VIP视频解析-前端页面,解析功能由第三方接口实现,本项目无后台,不收集任何数据。 此项目仅用于Web开发学习、交流 · 天朗气清登高远眺,秋日里的柳 · 广西一旧址获评国家级抗战纪念 · “蓝湖”上线!广西又迎来大风 · 广西防城港首开至安徽塔桥冷链 · 碧水青山,雅贤与桃花水母天窗 · 青云 【字幕翻译】:支持YouTube等多家主流平台的字幕翻译,双语字幕实时对照,无语言障碍看视频! 【在线翻译】:支持百种语言互译,搭配了Google翻译、百度翻译等多种强大引擎,保留历
视频速度转换器 如果您需要更改视频速度,我们的编辑器可让您快速轻松地进行调整。无需经验和学习 – 界面直观,因此您可以在上传剪辑后成为视频向导。我们的视频速度控制器具有用于更
好看视频是百度短视频旗舰品牌,拥有超百万的短视频创作者。全面覆盖知识、美食、生活、健康、文化、游戏、影视等海量视频,致力于为用户提供优质的视频内容与观看体验,让用户轻松
你想下载某视频,但是视频链接格式是.m3u8的,具体可随便找一个.m3u8格式的链接,进行操作。 接下来开始用ffmpeg下载它。 可邀请设置20个运营者微信号,共同发表和管理视频号。
- 希沃视频展台使用方法及常见问题-上海展台设计-维点展览公司
- 有道翻译_文本、文档、网页、在线即时翻译
- 例句-翻译为英语-例句中文| Reverso Context
- Jiangmenghao/vip-video-player
孟罗说,这本160页的英语俚语词典包括词条、定义、选段、例句、有关词源的注释和新俚语的来源。 熊孩子搞笑视频大合集,?最新美女搞笑视频笑到肚子疼?专治不开心沙雕操作视频合集#38,盘点人动物的搞笑视频合集,60个2019年爆火的梗(万恶之源)合集,带刚入b站的新人快速了解b站 抖音直播网页版 – 抖音已经支持在电脑上看直播啦!抖音直播PC版已支持热门网络游戏、棋牌游戏、单机游戏的直播内容。抖音-记录美好生活的视频平台
人人视频APP是一款提供影视剧资源的应用,用户可以在线观看各种类型的电影和电视剧。
YOUKU-在线视频网站-海量节目随心看

腾讯视频致力于打造中国领先的在线视频媒体平台,以丰富的内容、极致的观看体验、便捷的登录方式、多平台无缝应用体验以及快捷分享的产品特性,主要满 完全免费 这是一个100%免费的工具。没有登陆要求,没有邮件要求,也没有订阅要求。输出视频中也不包含任何水印。 5.3 (508人评价) 导演: 查传谊 主演: 梁思敏 / 叶先儿 / 陶大宇 类型: 情色 制片国家/地区: 中国香港 年份: 1992 2022-04-17 19:41:32 赞 回复 播放全片 腾讯视频 优酷视频 爱奇艺
- reverse-翻译为中文-例句英语| Reverso Context
- 爱奇艺-在线视频网站-海量正版高清视频在线观看
- 压缩 MP4:减少 MP4 视频大小的在线工具(免费)
- 动态首页-哔哩哔哩
- 抖音-记录美好生活
在线转换视频文件 – 将视频文件从一种格式转换为另一种格式,比如AVI到MP4,WEBM到MP4,MOV到MP4,MP4到MKV,WMV到MP4,MP4到GIF等。
『德语助手』权威的德语在线词典,为您提供德语翻译、德语动词变位、德语输入法、德语学校课程学习、德语题库字典、德语背单词、德语入门听力发音等。 MP4 压缩是通过改变 FPS、分辨率、CRF 或比特率来减小视频文件大小的过程,同时不会对视频质量造成太大影响。 每秒帧数或简称 FPS 是视频每一帧在屏幕上显示的频率或速度。 有网友质疑视频真假,也有网友担心学校招这么多学生是否能保证教学质量。 9月5日,牡丹区第二十二初级中学的一位工作人员表示,该校今年新入学的初一年级确实有94个
文心一言既是你的智能伙伴,可以陪你聊天、回答问题、画图识图;也是你的AI助手,可以提供灵感、撰写文案、阅读文档、智能翻译,帮你高效完成工作和学习任务。
reverse-翻译为中文-例句英语| Reverso Context
爱给网-免费视频素材下载专区,为创作者提供海量视频素材,包含高清实拍,视频模板,后期特效视频,背景视频,LED舞台,false模板,MG动画视频素材,VR视频等,一键 使用Reverso Context: reverse osmosis, reverse direction, reverse flow, reverse transcriptase, reverse gear,在英语-中文情境中翻译“reverse“ 使用 TopView 在线无缝转换视频链接为文字。以高准确度和速度将您的视频内容转换为文字。
爱奇艺(iQIYI)是中国领先的在线视频平台,提供海量免费正版高清电视剧、短剧、电影、综艺、动漫等视频内容,成功打造了狂飙、新说唱、偶像练习生、我是刑警、迷雾剧场等现象级IP,
哔哩哔哩是一个提供动漫、ACG内容和原创视频的弹幕网站,用户可以在这里找到丰富多样的视频资源和欢乐体验。 上YOUKU观看优质电影、电视剧、动漫、综艺内容,畅享多语种字幕及配音,热门节目等你来看!
新闻360 主持人:王沛 胡馨尹 苑逸伦 文坤 江苏新闻 播出时间:每日18:30—19:30 直击事件现场,关注民生热点,全媒体交互式黄金档民生新闻栏目。环节设置有:权威发布、记者调查、帮 直接在浏览器中轻松编辑视频 借助现代技术,在线视频编辑不再是幻想。任何人都可以在 Internet 上剪切和编辑个人镜头或简单的商业项目,而无需下载任何用于视频蒙太奇的传统软件。它不
抖音是一个鼓励表达、记录和创造的短视频平台,连接更大的世界,丰富精神生活,让现实生活更美好。
我们这才意识到,如果我们那些视频和照片被发布在了色情APP上,会不会也流向了推特这类社交媒体。 我开始在社交媒体上搜索,以为会像大海捞针,但很快,我就在一个色情博主页面上,
压缩 MP4:减少 MP4 视频大小的在线工具(免费)
- 清华大学出版社-图书详情-《凸优化》 : 凸优化 Boyd 王书宁译2013
- ️ Best Weight Distribution Hitch
- 還記得那台超帥的 5 億台限量版 Ps4 Pro 嗎?現在台灣用戶也有機會用競標買到了
- 查看Vsd在线应用程序-免费在线Vsd查看器 | 轻松打开VSD文件的7种方法,赶快收藏!_Visio_在线_工具
- 这个控件叫:Soft Keyboard/Virtual Keyboard/软键盘/虚拟键盘
- 蓝屏错误代码0Xc0000001怎么解决? : 修复Win10 inaccessible boot device错误的15种方法
- 新型Ghost Extended : 應熱情、活力新世代客戶要求!Rolls-Royce推出加長版Ghost Extended
- 自分の Windows デスクトップライセンスを使用する , OneDriveデータをPCに移動する完全ガイド:安全で効率的な方法
- 如何结合使用 Dfs-N 和 Azure 文件存储 | Azure Files で DFS-N を使用する方法
- 通関手続きの遅れを回避するための6つのコツ | 通関手続きと書類:知っておくべきこと
- ️ ¿Cuándo Cambiar La Correa De Distribución? Mantenimiento ️
- ️ Piscis: Descubre Su Personalidad En El Humor • Deincienso